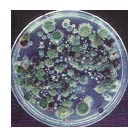

Torrt byggande minimerar risken för mögel och röta
Nedan följer ett utdrag ur skriften Mögel i hus: Orsaker och åtgärder skriven av Ingemar Samuelsson för Statens provningsanstalt, rapport 1985:16.
De flesta byggskador har samband med fukt på ett eller annat sätt. Ibland krävs mycket fukt för att skador skall inträffa, ibland sker skador vid relativt beskedliga fuktnivåer.
Följande punkter anger kritiska fukttillstånd uttryckt i relativ luftfuktighet för några vanliga skador:
- rötskador 100%
- förtvålning av golvlim 90-95%
- ammoniakavgivning från 75 – 85%
- flytspackel mögelpåväxt 70 – 80%
För mögelpåväxt krävs således måttlig fuktbelastning. Följande förutsättningar anser man krävs för att påväxt skall kunna ske:
- sporer
- syre
- nedbrytbart material
- temperatur > 0°C
- relativ fuktighet >70%
Det finns några svamparter som kan växa vid så pass låga fuktvärden som 70%. De flesta har dock sina optimala tillväxtbetingelser vid betydligt högre värden. Förutsättningarna för mögelpåväxt är lätta att uppfylla.
Sammanfattning
- sporer finns med största sannolikhet alltid närvarande
- luft finns närvarande
- nedbrytbart material finns oftast närvarande
- temperatur som är tillräcklig för mögelpåväxt
- den förutsättning som måste angripas är fukten
Ett torrt byggande och ett torrt hus är de viktigaste förutsättningarna för att undvika mögel och röta.
Undvika mögel
Gipsskivor har ytskikt av träfiberkartong. Träfibrerna är recirkulerade och har tidigare använts i tidningspapper, emballage eller trycksaker. De kan också ha använts i en tidigare gipsskiva och återvunnits därifrån. Inga fungicider tillsätts och därför kan träfibern brytas ner biologiskt på ett naturligt sätt. Gipsskivor kan återvinnas som krossat material bl.a. som gödning och jordförbättring. Kartongskiktet med träfiber tillsammans med gipsfraktionen bildar mull i en naturlig nedbrytningsprocess.
Även byggnader kan brytas ner av biologiskt angrepp där mögel och röta omvandlar biomaterial till enkla beståndsdelar. Gipsskivor är möjliga för mögelsvampar att livnära sig och växa på. Gipsskivor är dock inte något idealiskt växtunderlag för mögel. Vi undviker att få biologisk nedbrytning av byggnader framförallt genom att hålla dem torra.
De allra flesta nedbrytningsprocesser föredrar tillträde till vatten och syre. Ett enkelt åskådningsexempel är staketstolpen som står delvis i jorden. Den är beständig uppe i luften eftersom den för det mesta är torr där. Den är också beständig nere i marken eftersom det finns låg tillgång till syre. Men den bryts ner just i jordytan där det finns lämplig tillgång till både vatten och syre.
Tillgång till vatten och syre är väsentligt i en kompost där vi aktivt vill att biomassa skall brytas ner. Det är viktigt att inte låta en byggnad få kompostmiljö. Det är viktigt att hålla byggnadsmaterialen torra. Fukt kan komma från många håll både uppifrån, utifrån, underifrån och inifrån byggnaden. Byggnaden skall fuktdimensioners och underhållas så att den förblir torr. Det kan växa mögel på våta gipsskivor. Det kan aldrig växa mögel på torra gipsskivor.
Här hittar du anvisningar för hantering av gipsskivor vid fukt.